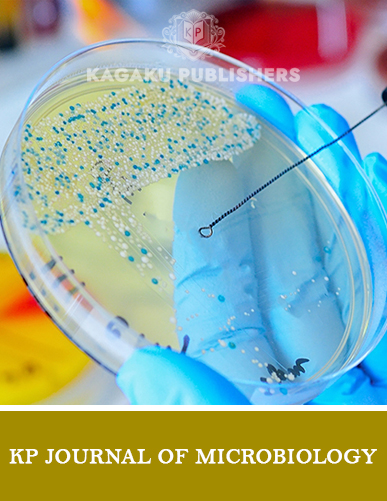

Browse Journals

KP Journal of Clinical and Medical
Case Reports
- casereports@kagakupublishers.com
- Discipline | Clinical Medicine
- Publisher | Kagaku International Open Access Publishers

KP Journal of Surgery
- surgery@kagakupublishers.com
- Discipline | Clinical Medicine
- Publisher | Kagaku International Open Access Publishers

KP Journal of Cancer
- cancer@kagakupublishers.com
- Discipline | Clinical Medicine
- Publisher | Kagaku International Open Access Publishers

KP Journal of Dentistry and Oral Health
- dentistry@kagakupublishers.com
- Discipline | Clinical Medicine
- Publisher | Kagaku International Open Access Publishers

KP Journal of Gastroenterology
- gastroenterology@kagakupublishers.com
- Discipline | Clinical Medicine
- Publisher | Kagaku International Open Access Publishers

KP Journal of Forensic
- forensic@kagakupublishers.com
- Discipline | Clinical Medicine
- Publisher | Kagaku International Open Access Publishers

KP Journal of Nursing
- nursing@kagakupublishers.com
- Discipline | Clinical Medicine
- Publisher | Kagaku International Open Access Publishers

KP Journal of Nutrition
- nutrition@kagakupublishers.com
- Discipline | Clinical Medicine
- Publisher | Kagaku International Open Access Publishers

KP Journal of Obstetrics and
Gynaecology
- gynaecology@kagakupublishers.com
- Discipline | Clinical Medicine
- Publisher | Kagaku International Open Access Publishers

KP Journal of Cardiology
- cardiology@kagakupublishers.com
- Discipline | Clinical Medicine
- Publisher | Kagaku International Open Access Publishers

KP Journal of Pediatrics
- pediatrics@kagakupublishers.com
- Discipline | Clinical Medicine
- Publisher | Kagaku International Open Access Publishers
KP Journal of Microbiology
- microbiology@kagakupublishers.com
- Discipline | Clinical Medicine
- Publisher | Kagaku International Open Access Publishers

KP Journal of Neurology
- neurology@kagakupublishers.com
- Discipline | Clinical Medicine
- Publisher | Kagaku International Open Access Publishers

KP Journal of Cosmetic Dermatology
- dermatology@kagakupublishers.com
- Discipline | Clinical Medicine
- Publisher | Kagaku International Open Access Publishers

KP Journal of Nephrology and Urology
- nephrology@kagakupublishers.com
- Discipline | Clinical Medicine
- Publisher | Kagaku International Open Access Publishers